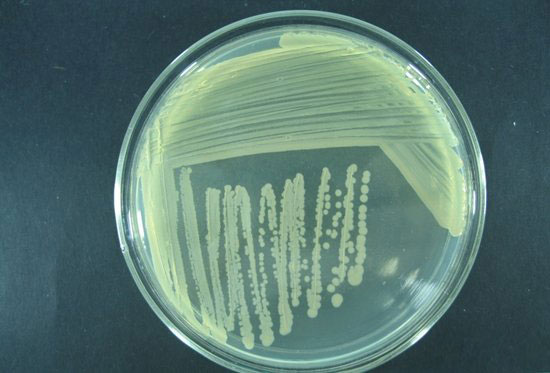
嗜水氣單胞菌

病原微生物又可稱為病原菌,是指能入侵宿主引起感染的微生物,有病毒、細菌、真菌等。以下要對水產養殖中的病原細菌進行闡述。
1、斑點氣單胞菌
特點:產氣單胞菌屬,革蘭氏陰性菌,發酵型產酸。*端單鞭毛,逗點狀,無芽孢,染色均勻。
生存環境:存在行于正常魚的腸道、皮膚或水體、水下污泥中。
引發病癥:條件致病,主要引起腸炎病。
腐生,當條件適宜時,大量繁殖,毒力增強,由腐生轉為寄生,變為致病菌。這些大量繁殖的致病菌穿過腸壁到血液,經由血液循環到達內臟器官,在器官內繁殖并釋放毒素,引起魚類的敗血死亡。
主要危害草魚、鰱魚、鳙魚、青魚等養殖魚類。有實驗表明,25~30℃時,可引起發病草魚的大量死亡,隨著溫度的升高,草魚由發病到死亡的時間變短。
2、溫和氣單胞菌
特點:產氣單胞菌屬,發酵型產酸。革蘭氏陰性菌,兼性厭氧。*端單鞭毛,無芽孢。
生存環境:常出現在淡水,海水、污水、土壤之中,而在食物里面也可以找到,是一常見的腐物寄生菌,生長溫度為38~41℃。
引發病癥:條件致病,具傳染性,主要引起尾柄病。
被感染的魚皮膚和鰭上會出現針狀小點的出血,腹部腫脹,凸眼。在魚體內則會腹部積水,如肺水腫、脾水腫、腸的腫脹,腹部充滿液體。
魚尾部損傷后,細菌感染繁殖,并不斷向水體排放病菌,通過水體和魚體進行傳播。開始病菌在侵入部位引起發炎,進而引起正常組織細胞變性、壞死。局部循環發生障礙,白細胞等聚集,細菌侵入組織間隙,引起肌肉腐爛。病魚失去平衡,頭部向上于水面升起,有的在尾部繼發水霉。
3、嗜水氣單胞菌
特點:產氣單胞菌屬,為革蘭氏陰性短桿菌,*端單鞭毛,沒有芽胞和莢膜。
生存環境:嗜水氣單胞菌廣泛分布于自然界的各種水體,是多種水生動物的原發性致病菌,為條件致病菌,是典型的人-獸-魚共患病病原菌。
在水溫14~40℃范圍內都可繁殖,以28~30℃為適合溫度;pH值在6~11范圍內均可生長,適合pH值為7.2;可在含鹽量0‰-4‰的水生存,適合鹽度為0.5‰。
引發病癥:條件致病,具傳染性,可以產生毒性很強的外毒素。引發白鰱暴發性出血病、甲魚敗血病、黃鱔出血病、鰻鱺紅鰭病等。也可引起豎鱗病。
嗜水氣單胞菌侵入魚體后,先在腸道內增殖,再經門動脈循環進入肝臟、腎臟及其它組織,引起肝臟、腎臟等器官以及血液病變,繼而出現全身癥狀。
當環境驟變,水質惡化時,常會與其它菌(如溫和產氣單胞菌、弧菌等)混合感染使病情加重。由嗜水氣單胞菌感染的疾病一般病勢較猛,多為惡性傳染病,死亡率很高。
4、熒光假單胞菌

特點:假單胞菌屬,革蘭氏陰性,有數根*生鞭毛,運動,不產芽孢。
生存環境:是一種環境污染菌。適宜溫度25~30℃,40℃尚能生長。廣泛分布于水體、水下污泥中。需氧,進行嚴格的呼吸型代謝,或以硝酸鹽為替代的電子受體進行厭氧呼吸。化能營養異養,不需要有機生長因子。
引發病癥:條件致病,自溶后產生毒素,主要引起赤皮病。
當魚體受傷時,體表失去了屏障作用,病菌侵入皮膚損傷處,在該處生長繁殖,而后進入魚體內,產生敗血癥。
主要危害草、青、鯉魚。一年四季均可發生。流行發病溫度是25~30℃。
5、白皮假單胞菌
特點:假單胞菌屬,革蘭氏陰性,*生鞭毛。
生存環境:是一種常見的病菌,它喜好生存在潮溼環境中,通常分布于泥土、水、空氣以及植物上,經由傷口傳染。
引發病癥:從背鰭后部至尾柄鰭基部的皮膚發白,呈白霧狀,手摸鱗片粗糙、無黏液,將死的病魚,往往頭部朝下、尾鰭向上呈倒立狀。
主要危害鰱、鳙魚種,草魚、青魚也會感染。此病主要發生在鱖魚夏花魚種至大規格魚種階段。病程短,發病時來勢兇猛,流行地區廣,從發病到死亡僅2~3天,死亡率高,魚種死亡率可達50%以上。每年5~8月為流行期。
6、水型點狀假單胞菌
特點:假單胞菌屬,革蘭氏陰性。短桿狀,近圓形、單個排列,有動力,無芽胞。
生存環境:該菌是水中常在菌,是條件致病菌。當水質污濁、魚體受傷時經皮膚感染。
引發病癥:豎鱗病。
病魚體表粗糙,鱗片豎立,外觀呈松球狀,嚴重時眼球突出、呼吸急促、背部翻轉過來,以至死亡。鱗囊水腫,其內部積存著透明或含血的滲出液,如果在鱗片上稍加壓力,就會有液體從鱗囊中噴射出來。病魚沉于水底或身體失去平衡,腹部向上,衰竭而死。
主要是危害鯉魚、鯽魚、金魚,草魚、鰱魚有時也患此病,從較大的魚種至親魚均可受害。主要流行于靜水養魚池中,流水養魚池中較少發生。在秋末至春季,水溫17~22℃流行。
7、柱狀纖維粘細菌(柱狀屈撓桿菌)
特點:革蘭氏陰性,兼性好氣生長,在無氧條件下生長很慢。
生存環境:適合生長溫度28~35℃。pH6.5~7.5生長良好,pH8生長較差,pH6以下和8.5以上不生長。0.7%以上的食鹽可以抑制其生長。
引發病癥:條件致病,具傳染性,引起爛鰓病、白頭白嘴病。
取鰓部粘液鏡檢,可見到分散的、成堆的或柱子形的粘細菌,似火柴棒,菌體柔軟,活潑。
青、草、鰱、鳙等都可發病,流行發病溫度是28~35℃。主要寄生在魚的鰓、體表、鰭條和頭部。寄生處一般有潰瘍和缺損。可引起浮頭,主要發生在放養過密和水質不好的水中。
8、愛德華氏菌
特點:愛德華氏菌為小直桿菌,革蘭氏染色陰性,兼性厭氧,靠周生鞭毛運動,但鲇魚愛德華氏菌在25℃時有動力,在37℃時無動力。除鲇魚愛德華氏菌外,其他種*適生長溫度為37℃。
生存環境:可存活于動物腸道、糞便及淡水中。無癥狀的帶菌魚通過糞便散播細菌,細菌在養殖池塘中持續存在并能不斷引起該病發生與流行,該菌能在沉積物中存活很長時間。
引發病癥:機會致病菌,病后表現的癥狀及病變等在各種魚中有所不同。
已報道的主要有兩種類型:
一是常見的腸道感染后發生急性敗血癥,除了一般的細菌感染所表現出的特征外,貧血和眼球突出是常見的癥狀,在肝臟及其他內臟器官表現有出血點和壞死點分布。
二是慢性感染,在鼻根的嗅覺囊,繼之緩慢發展到腦組織形成肉芽腫性炎癥,伴有交替的倦怠和不規則游動,在后期典型的“頭穿孔”病例可見到頭背顱側部爛的很深,一直暴露出腦部。
流行水溫18~28℃,在此溫度范圍以外帶菌的魚群體只有少數發病死亡。對鰻鱺、鲇魚和其他動物致病,對人屬罕見致病。
9、星狀諾卡氏菌
特點:諾卡氏菌是好氣菌,革蘭氏陽性,抗酸或部分抗酸,大部無氣絲,有些之中生氣生菌絲體,基絲分枝,橫隔斷裂成桿狀體和球狀體。
生存環境:大多為腐生菌,存在于土壤中。
引發病癥:可分為軀干結節型和鰓結節型。
軀干結節型主要癥狀為在軀干皮下組織及肌肉發生潰瘍,形成外觀開關不規則白色阡的癤瘡,剖開癤瘡流出白色濃汁。內臟器官如心臟、脾臟、腎臟及鰾處也有白色結節。
鰓結節于鰓絲基部形成乳白色大結節,形成鰓循環障礙后鰓絲呈蒼白色。可侵犯皮膚、軟組織、中樞神經系統及心臟等,導致病變部位的化膿性炎癥及膿腫形成。
病魚上浮水面,反應遲鈍,食欲下降,眼球突出,鰭基部和腹部有少量出血,腹部腫大。解剖發現腹腔內有積水,腎臟和肝臟上有一顆顆乳白色的突起,直徑大小在1一3毫米。流行季節較長,從4月至11月均有發生,發病高峰在6~9月,水溫28~32℃,發病池水質惡化,飼料為海水冰鮮魚,發病呈慢性型。
10、無乳鏈球菌
特點:革蘭氏陽性,呈鏈狀或成對排列的球菌。
生存環境:其在自然界中分布廣泛,普遍存在于水、動物體表,泌尿生殖道和乳汁中,對哺乳動物、爬行動物、兩棲動物和魚類均有致病性,是一種人-獸-魚共患病病原。
引發病癥:鏈球菌感染的魚類,頭部癥狀明顯,眼球腫大突出。致病菌能破壞魚體的腦神經,繼而通過血液循環破壞肝、腎、脾等器官引發全身性出血病,是一種傳染性*強的細菌性疾病。
該病多發生于羅非魚親魚及體重100g以上的幼魚和成魚。在水溫長期過高、缺氧或養殖密度過大等情況下易暴發,流行高峰為5~9月,流行水溫25~37℃。病魚的死亡率達80%以上,死亡高峰可持續2~3周;在低溫季節,死亡率相對較低,但是持續時間則更長。
聲明:部分內容、圖片、音視頻素材來源于互聯網收集整理,僅供參考,不代表本站對其內容(觀點)正確性的完全認可!如有相關需求,請聯系我們并以具體溝通為準!如內容侵犯了原著者權益,請聯系我們刪除。